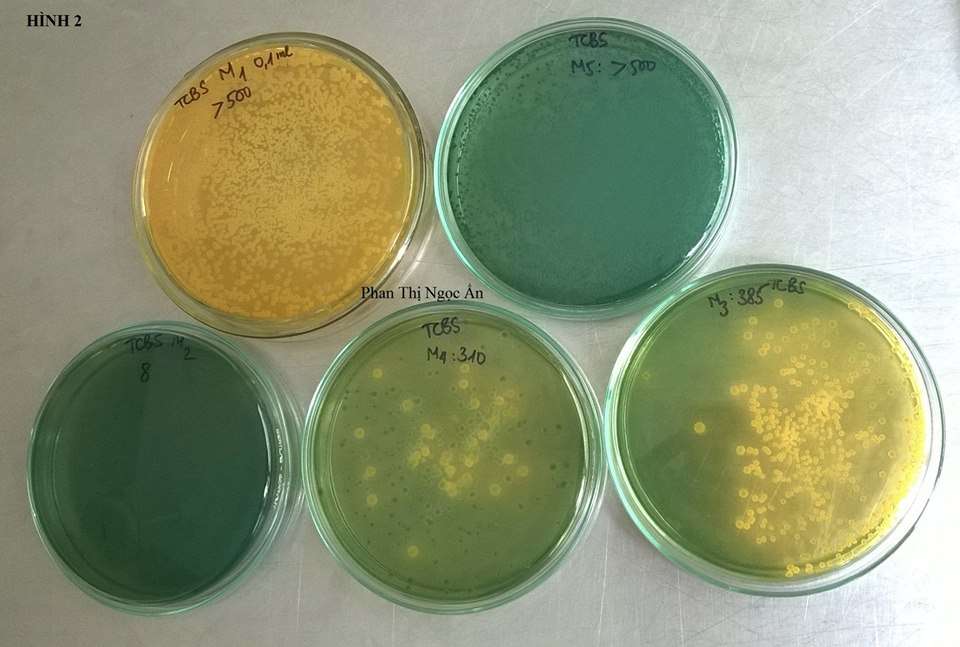

HƯỚNG DẪN CÁCH SỬ DỤNG ĐĨA THẠCH CHỨA MÔI TRƯỜNG TCBS AGAR ĐỂ KIỂM TRA NƯỚC AO NUÔI
Môi trường TCBS Agar (Thiosulfate-Citrate Bile–Sucrose Agar) là một môi trường chọn lọc để phân lập vi khuẩn Vibrio cholerae và enteropathologic Vibrio khác (đặc biệt là Vibrio parahaemolyticus) trong tôm, cá, hải sản và các mẫu sinh học có nguồn gốc động vật.
- THÀNH PHẦN MÔI TRƯỜNG TBCS AGAR
Trong 1 lit môi trường (có thể thêm thành phần để phù hợp)
– Polypeptone: 10.0 g
– Yeast extract: 5.0 g
– Saccharose: 20.0 g
– Bacteriological ox bile: 5.0 g
– Sodium cholate: 3.0 g
– Sodium citrate: 10.0 g
– Sodium thiosulfate: 10.0 g
– Sodium chloride: 10.0 g
– Ferric ammonium citrate: 1.0 g
– Bromthymol blue: 40.0 mg
– Thymol blue: 40.0 mg
– Bacteriological agar: 14.0 g
pH của môi trường hoàn chỉnh ở 25 độ C: 8.6 ±0.2
- HƯỚNG DẪN CÁCH SỬ DỤNG ĐĨA THẠCH CHỨA MÔI TRƯỜNG TCBS AGAR ĐỂ KIỂM TRA NƯỚC AO NUÔI
- Bước 1: Lấy mẫu nước ở giữa hoặc đáy của ao cần kiểm tra.
- Bước 2: Cho từ từ khoảng 2- 3 ml nước mẫu vào ngay trên bề mặt đĩa thạch TCBS, tránh dây nước lên thành đĩa.
- Bước 3: Lắc nhẹ theo hướng xoay tròn để nước đươc trải đều trên bề mặt thạch.
- Bước 4: Nghiêng đĩa về một phía, sử dụng khăn giấy hoăc vải khô thấm hết lượng nước dư rồi lau khô thành đĩa.
- Bước 5: Đậy nắp đĩa lại, úp ngược. Sử dụng giấy gói đĩa thạch chứa môi trường TCBS Agar lại và bảo quản trong điều kiện nhiệt độ phòng khoảng 35 độ C.
- Bước 6: Sau 18- 24 giờ, dài nhất là 48 giờ, mở đĩa ra, quan sát màu sắc và đếm số khuẩn lạc trên đĩa. Sau đó nhân với 4 để xác định tổng số khuẩn lạc/gam.
- Bước 7: Khử trùng đĩa bằng Chlorine hoạt tính 0.5ppt (1% dung dịch thuốc tẩy) sau khi đếm.
- HƯỚNG DẪN CÁCH SỬ DỤNG ĐĨA THẠCH CHỨA MÔI TRƯỜNG TCBS AGAR ĐỂ KIỂM TRA KHUẨN TRÊN TÔM:
- Bước 1: Lấy một ít gan tôm cho vào ống có chứa dung dịch pha sẵn.
- Bước 2: Dùng chày nhựa nghiền mẫu gan cho thật nhuyễn trộn đều
- Bước 3: Đổ dung dịch chứa mẫu gan tôm đã nghiền vào đĩa thạch màu xanh, trắng đều. Đổ bỏ dung dịch còn dư trên đĩa thạch
- Bước 4: Lật ngược đĩa thạch, ủ 24h, sau đó lọc kết quả
- Kiểm trả thấy vi khuẩn Vibrio spp phát triển thành những khuẩn lạc (đốm tròn) màu vàng hoặc màu xanh có đường kính 2 – 5mm tùy theo loài
- Đa số khuẩn lạc (đốm tròn) màu xanh trên đĩa thạch là khuẩn gây hại cho tôm
- MÔI TRƯỜNG TCBS AGAR CHỌN LỌC VI KHUẨN VIBRIO NHƯ THẾ NÀO?
Căn cứ vào đặc điểm hình thái của lạc khuẩn để xác định chủng vi khuẩn Vibrio như sau:
|
VI KHUẨN |
ĐẶC ĐIỂM HÌNH THÁI |
|
Vibrio cholera |
Khuẩn lạc vàng phẳng, đường kính 2-3 mm |
|
Vibrio alginolyticus |
Khuẩn lạc vàng lớn |
|
Vibrio fluvialis, Vibrio vulnificus |
Khuẩn lạc vàng hoặc trắng mờ |
|
Vibrio parahaemolyticus |
Khuẩn lạc không màu với trung tâm màu xanh |
|
Pseudomonas, Aeromonas |
Khuẩn lạc màu xanh nước biển |
|
Enterobacteria or others |
Khuẩn lạc trong suốt nhỏ |
- NHỮNG LƯU Ý KHI SỬ DỤNG ĐĨA THẠCH CHỨA MÔI TRƯỜNG TCBS AGAR
– Khi sử dụng đĩa thạch TCBS, người thực hiện nên chọn các chất nuôi cấy đặc vì những loài Vibrio dễ chết đột ngột và môi trường này có để ngăn chặn được điều đó.
– Mẫu xét nghiệm tươi là tốt nhất, vì vi sinh vật này nhạy cảm với điều kiện khô, ánh sáng và pH acid. Nếu xử lý chậm thì nên sử dụng môi trường Cary-Blair để vận chuyển bệnh phẩm tốt hơn là môi trường vận chuyển có đệm glycerol.
– Không lấy khuẩn lạc ở môi trường TCBS để làm thử nghiệm oxydase.
Trên đây là những thông tin về môi trường TCBS Agar từ thành phần đến cách môi trường TCBS Agar chọn lọc vi khuẩn Vibrio

Xem thêm